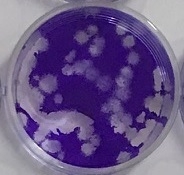
プラーク試験例(生理食塩水)

アルカリ電解水で国内初!!※1 「ZENON 特殊アルカリ電解水」が、新型コロナウイルス (SARS-CoV-2)に対する不活化効果<15秒>を確認。 奈良県立医科大学との共同研究により実証
株式会社ゼノン(本社:東京都中野区/代表取締役社長:阿部 昭典)は、公立大学法人奈良県立医科大学及び一般社団法人MBTコンソーシアムの協力のもと、「ZENON 特殊アルカリ電解水」が、新型コロナウイルス(SARS-CoV-2)への不活化(※2)に効果があることを国内で初めて(※1)確認しました。
当社では、これまでも特殊アルカリ電解水について、各種エビデンスの取得に注力してまいりましたことから、新型コロナウイルスで、多数の研究実績を持つ前述の機関へ共同研究を提案し、本結果を得るに至りました。
(※1/国内初=2021年4月14日時点 当社調べ)
[注]
- 奈良県立医科大学(理事長・学長 細井 裕司):昭和20年4月設立、橿原市
- MBTコンソーシアム(理事長 細井 裕司):医学的知識をすべての産業に投入してイノベーションを起こすMBT(Medicine-Based Town、医学を基礎とするまちづくり)の理念を達成するために設立された一般社団法人で、現在ほぼすべての業種から170社以上が参加している。
- ウイルスの不活化(※2):ウイルスの感染性を失わせること。
- ZENON 特殊アルカリ電解水:水と食品添加物でもある炭酸カリウムだけを使い、独自の生成装置を使用して製造されたアルカリ性の電解水。
(当社現製品名:ピュアステラ ※ただし、当社はOEM供給を行っているため製品名は複数あります)
奈良県立医科大学「新型コロナ感染対策の研究結果」公開サイト
https://www.naramed-u.ac.jp/university/kenkyu-sangakukan/oshirase/mbtsars-cov-2-page3.html#zenon
新型コロナウイルスに対する不活化効果の評価<即効!!15秒で99.9%以上を不活化>
[公立大学法人奈良県立医科大学 微生物感染症学講座]
※不活化評価の試験に関する詳細は、別紙「研究報告書」をご参照ください。
一定の条件下で「ZENON 特殊アルカリ電解水」を新型コロナウイルスに15秒接触させると、感染価が99.9%以上減少しました。この結果により、本電解水は、新型コロナウイルス(SARS-CoV-2)を短時間で不活化することが判明しました。実使用においては、本電解水によって拭き取り清掃を行うことにより、物質の表面についた新型コロナウイルスによる接触感染防止に、有効である可能性が考えられました。
また、「ZENON 特殊アルカリ電解水」は、ノロウイルス・インフルエンザウイルスの不活化試験の他、大腸菌・サルモネラ菌などの食中毒の原因菌への除菌効果試験、及びパッチテストなどの皮膚刺激性試験などを、これまでも他所で行い、同様に高い性能結果が実証されていることから、アルコールが使用・保管しにくい場所やシーン(臭気・使用期間・運搬など)での利用の他、皮脂など汚れと共にウイルスや細菌がつきやすい接触面(テーブル・手すり・便座・床など)での、感染抑制効果に期待がもてるのではないかと考えています。
(一定の条件下での検証結果。全ての菌・ウイルスに対して効果があるわけではありません)
資料 「ZENON 特殊アルカリ電解水<除菌洗浄水>」について
ZENON 特殊アルカリ電解水
成分 :水(炭酸カリウム1%未満)
※炭酸カリウムは、電解促進剤としてのみ使用
用途 :<除菌洗浄水>
物体の表面に付着した汚れの洗浄、及びウイルスや菌の除去
使用方法:対象面に直接スプレーして拭き取るか、
清潔なクロスやティッシュに吹きつけて拭きあげ、
または水道水などで流す(2度拭き不要)



■当社現製品名:ピュアステラ(ラインナップ)
※当社はOEM供給を行っているため、製品名は複数あります。
◆500ml(pH12.7) ◆2L(pH12.7) ◆4L(pH12.7/pH13.2) ◆20L(pH12.7/pH13.2)
・pHが異なる2種類の電解水を、独自の生成装置で製造しています
製品特徴
(1)幅広いウイルス・細菌への有効性が実証されている
アルコールでは効きにくいノロウイルスなど、詳細は当社ホームページを参照ください。
(一定の条件下での検証結果。全ての菌・ウイルスに対して効果があるわけではありません)
(2)経時変化・劣化が少ない(ロングライフ性能)
時間経過による品質劣化が問題となる次亜塩素酸水など様々な電解水(pH値が変化し洗浄や除菌効果が落ちてしまう。この傾向は、酸性・アルカリ性製品を問わずある)の中で、約6年間の性能維持を確認。計画的な在庫消費型洗浄剤として、また災害備蓄品などとしてムダにならない活用が可能です。
(3)汚れに強く、表面残留物が少ない
汚れの内部に強力に浸透し、油汚れなどのしつこい汚れもきれいに落とします。成分は水だけで、界面活性剤・化学薬品・アルコールを一切使用していませんので、表面に有害物質が残りません。
(4)水なのに錆びず、消臭効果があります
酸性の水はサビの原因になりますが、酸性とは対極にあるアルカリ性の水のため、金属を錆から守る効果が期待できます。また、臭いの元となるバクテリアなどを強力分解。無色・無臭で、消臭効果を発揮します。
(アルカリに反応しやすい金属(アルミニウム・真鍮・銅など)には使用できません)
(5)様々な分野で使用されています
強力な洗浄力と、除菌・消臭効果などから、食品加工場・飲食店などの食品分野、ホテル・ビルメンテナンスなどの施設分野、切削工場などの工業分野、学校などの教育施設などの生活分野など、様々な分野で使用されています。
(6)労働環境・環境保護にも優しい
界面活性剤や化学薬品を一切含まないため、生活空間や工場などの労働空間に残存することはありません。自然環境中に排出しても水に戻るため、環境保護にも有効と考えています。
(7)引火性・発泡がないため扱いやすい
水のため、引火による火災リスクや輸出制限を気にすることなく使うことができます。また、一般的な洗剤で発生する「泡」がでないため、「すすぎの面倒や二度拭き」の必要がありません。
研究報告書
奈良県医科大学との共同研究
「ZENON 特殊アルカリ電解水」による新型コロナウイルスに対する不活化効果の評価
終了日(報告日)2021年4月13日
試験概要
- 研究目的 :特殊アルカリ電解水による新型コロナウイルスの不活化効果がどの程度あるか明らかにすること。
- 試験機関 :奈良県立医科大学医学部 微生物感染症学講座
- 試験品 :ZENON 特殊アルカリ電解水(pH12.7)
- 試験ウイルス:新型コロナウイルス(SARS-CoV-2;分離株)
- 実験施設 :全試験は、大学内のバイオセーフティーレベル3(BSL3)の施設において、適切な病原体封じ込め措置のもとで行いました。
- 試験内容 :
(1)消毒剤の評価法ASTM E1052に準じて、次の手順で特殊アルカリ電解水の抗ウイルス効果を評価しました。
(2)ウイルス液1に対して試験品9の割合で混合させ、試験品に対して25℃で、表1の作用時間後、反応を停止させ、ウイルス感染価(PFU/mL)をプラーク法にて測定しました。
表1. 試験品に対する作用時間
試験品 :PBSコントロール*(1)
作用時間*(2):0秒 ○
15秒 -
30秒 -
60秒 ○
試験品 :特殊アルカリ電解水
作用時間*(2):0秒 ○
15秒 ○
30秒 ○
60秒 ○
*(1)PBS:リン酸緩衝生理食塩水
*(2)15秒と30秒のPBSは60秒のPBSで代用しました。
〇:測定5ポイント×実施2回


試験結果
8.50E+06 PFU/mlの新型コロナウイルスに特殊アルカリ電解水を混合すると、15秒後には、検出限界の1.00E+02 PFU/ml未満(減少率>99.998%)へと感染価が減少しました。


不活化効果は以下のように算出しました。
不活化効果(Mv)=log(Ct/C0 - log(Nt/N0)=logCt/Nt
Ct:コントロールt時間後の感染価
C0:コントロール0時間後の感染価
Nt:試験品t時間後の感染価
N0:試験品0時間後の感染価
減少率は対数減少値(=Mv)より次の通り算出しました。
減少率=(1-1/10対数減少値)×100%
まとめ
本試験において使用した特殊アルカリ電解水は、新型コロナウイルス(SARS-CoV-2)に対して不活化効果が認められました。本試験液により、物質の表面についた新型コロナウイルスによる接触感染防止に、有効である可能性が考えられました。なお、空間に浮遊するウイルスへの効果、人体への影響については検証を行っていません。
会社概要
●商号 : 株式会社ゼノン
●代表者 : 代表取締役社長 阿部 昭典
●本社 : 〒165-0032 東京都中野区鷺宮5-6-23
(営業DIV:〒176-0012 東京都練馬区豊玉北4-26-6 1F)
●設立 : 1989年11月(平成元年11月27日)
●事業内容: 特殊アルカリ電解水の製造販売
●資本金 : 1,000万円
●URL : https://znn.co.jp/